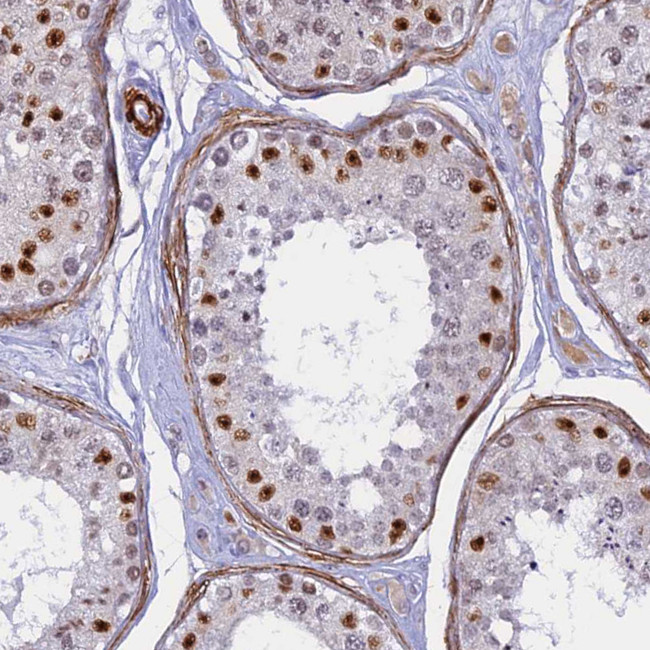
CENPV Antibody in Immunohistochemistry (Paraffin) (IHC (P))

Search
Invitrogen
CENPV Polyclonal Antibody
{{$productOrderCtrl.translations['antibody.pdp.commerceCard.promotion.promotions']}}
{{$productOrderCtrl.translations['antibody.pdp.commerceCard.promotion.viewpromo']}}
{{$productOrderCtrl.translations['antibody.pdp.commerceCard.promotion.promocode']}}: {{promo.promoCode}} {{promo.promoTitle}} {{promo.promoDescription}}. {{$productOrderCtrl.translations['antibody.pdp.commerceCard.promotion.learnmore']}}







Please note: We are reviewing Western blot images included in the antibody testing data in our catalog, including those provided by third parties. Unless expressly labeled or annotated as “raw-unedited”, Western blot images included in the antibody testing data in our catalog may have been edited, optimized or otherwise adjusted for presentation.
产品信息
PA5-60049
种属反应
宿主/亚型
分类
类型
抗原
偶联物
形式
浓度
规格
纯化类型
保存液
内含物
保存条件
运输条件
RRID
产品详细信息
Immunogen sequence: NLDLGEQRER WETFQKRQKL TSEGAAKLLL DTFEYQGLVK HTGGCHCGAV RFEVWASADL HIFDCNCSIC KKKQN
Highest antigen sequence identity to the following orthologs: Mouse - 95%, Rat - 71%.
靶标信息
CENPV orthologs were detected in a range of species, including plants, but the proline-rich region was detected only in primates, rodents, birds, and amphibians, and long proline stretches were found only in primates. Northern blot analysis showed ubiquitous Cenpv expression in mouse tissues, with highest expression in testis, followed by small intestine, brain, and kidney. Immunofluorescence microscopy of mouse fibroblasts revealed colocalization of Cenpv with stabilized cytoplasmic microtubules. Western blot analysis of Ramos B cells detectedCENPV at an apparent molecular mass of 40 kD.
仅用于科研。不用于诊断过程。未经明确授权不得转售。
篇参考文献 (0)
生物信息学
蛋白别名: CENP-V; Centromere protein V; Nuclear protein p30; Proline-rich protein 6
基因别名: CENPV; PRR6
Entrez Gene ID: (Human) 201161